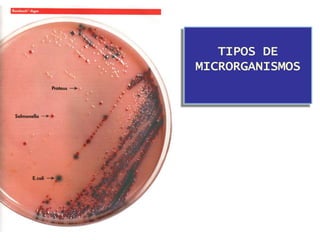
TIPOS DE
MICRORGANISMOS

O documento discute os microrganismos que podem contaminar alimentos e causar doenças, incluindo bactérias como Salmonella, E. coli e Staphylococcus. Ele explica como esses microrganismos se espalham através de água, ar, solo, animais e seres humanos, e fornece diretrizes sobre temperaturas seguras e boas práticas de higiene para manipuladores de alimentos.